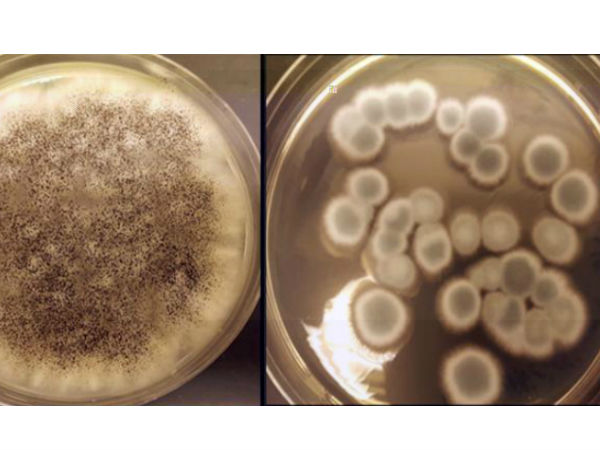
மதிப்பு :
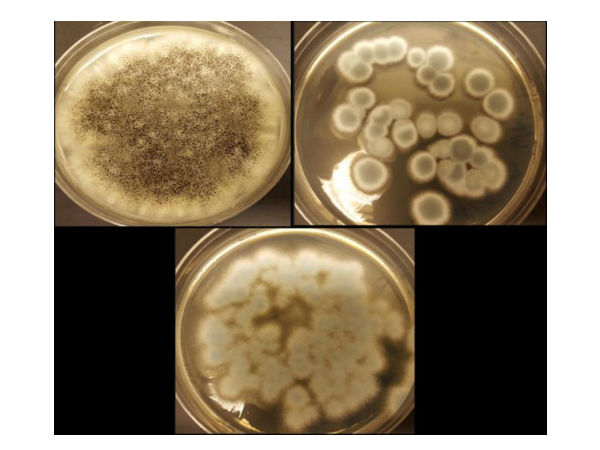
கோபால்ட் மற்றும் லித்தியம் :
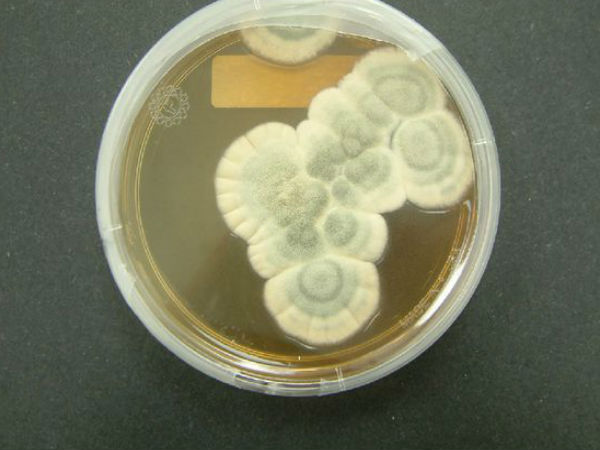
கடினம் :
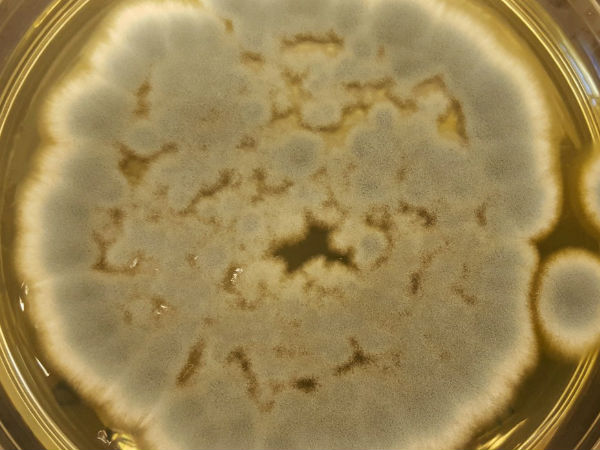
வளர்ச்சி :

சாதனை : 'மரணமே இல்லாத' பேட்டரிகள் - பூஞ்சைகளில் இருந்து..!
பூஞ்சைகளை (Fungus) பயன்படுத்தி, ரீச்சார்ஜபில் லித்தியம்-அயான் பேட்டரிகளை குறைந்த செலவில், சுற்றுச்சூழலுக்கு நட்பான முறை மறுசுழற்சி செய்யும் வழிமுறை ஆராய்ச்சியாளர்கள் கண்டுபிடித்துள்ளனர்.
இம்முறையை கொண்டு ஸ்மார்ட்போன்கள், கார்கள் மற்றும் டேப்ளெட்களின் ரிச்சார்ஜபிள் பேட்டரிகளை மீண்டும் மீண்டும் சார்ஜ் செய்ய முடியும், அதாவது பேட்டரிகளை என்றைக்குமே பயன்படுத்திக் கொண்டே இருக்க முடியும்.
மதிப்பு :
பெரும்பாலான பழைய பேட்டரிகள் எரிதொட்டிகளாய் அல்லது நிலநிரப்புதல்களாய் ஆகிறது ஆகமொத்தம் சுற்றுசூழலுக்கு சாத்தியமுள்ள பாதிப்பை ஏற்படுத்தி அதனுள் பூட்டப்பட்டுள்ள மதிப்புமிக்க பொருட்களையும் பாதிக்கிறது.
கோபால்ட் மற்றும் லித்தியம் :
தற்போது, அமெரிக்காவின் தெற்கு புளோரிடா பல்கலைக்கழக ஆராய்ச்சியாளர்கள் குழு ஒன்று இயற்கையாகவே பூஞ்சைகளில் நிகழும் கழிவுகள் மூலம் பேட்டரிகள் மறுசுழற்சிக்கு டன் கணக்கில் கோபால்ட் மற்றும் லித்தியம் பெறும் வழியை கண்டறிந்துள்ளது.

யோசனை :
வெட்டுதல் நடவடிக்கைகளில் இருந்து வரும் கழிவுகளில் இருந்து சில உலோகங்களை பிரித்தெடுக்கும் நுட்பத்தில் அனுபவம் கொண்ட ஒரு மாணவரால் தான் இந்த யோசனை முதன்முதலில் பிறந்தது.
கடினம் :
லித்தியம் தேவை வேகமாக அதிகரித்துக் கொண்டே போகிறது மற்றும் புதிய லித்தியம் வள சுரங்கங்களை நிலையாக வைத்திருப்பது கடினம்.
வளர்ச்சி :
ஸ்மார்ட்போன்கள் மற்றும் ரிச்சார்ஜபிள் பேட்டரிகள் போன்ற பொருட்களின் பெரிய அளவிலான வளர்ச்சியை பார்த்து பின் ஆராய்ச்சியாளர்கள் தங்கள் கவனத்தை அதிகமாக இந்த கண்டுபிடிப்பில் செலுத்தியுள்ளன என்பதும் குறிப்பிடத்தக்கது.

மேலும் படிக்க :
ஷூ போட்டு நடந்தால் போன் சார்ஜ் ஆகும் 15 வயது சிறுவன் அசத்தல் கண்டுபிடிப்பு.!!
அசத்தல் : ஜெல்லி மீன் புரதங்களை அடிப்படையாக கொண்டு அடுத்ததலைமுறை லேசர்..!
'டக்கர்' தாத்தா : அறிவுக்கும் திறமைக்கும் சம்பந்தமே கிடையாது..!

தமிழ் கிஸ்பாட் :
மேலும் இதுபோன்ற அறிவியல்-தொழிற்நுட்ப செய்திகளை உடனுக்குடன் பெற - தமிழ் கிஸ்பாட் ஃபேஸ்புக் பக்கம் மற்றும் தமிழ் கிஸ்பாட் வலைதளம்..!



 Click it and Unblock the Notifications
Click it and Unblock the Notifications





























-1763362932432.svg)